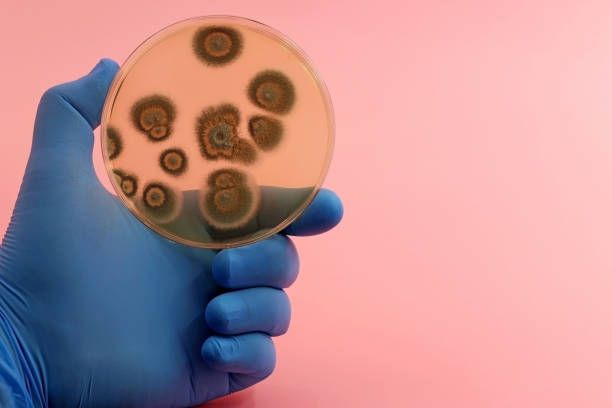

This systematic review focuses on breakthrough invasive fungal infections (bIFIs) in patients with high-risk hematological cancers, like acute leukemia, or those who have undergone stem cell transplants. Despite prophylactic antifungal treatments (usually with voriconazole or posaconazole), bIFIs remain challenging due to their complexity and high mortality rates.